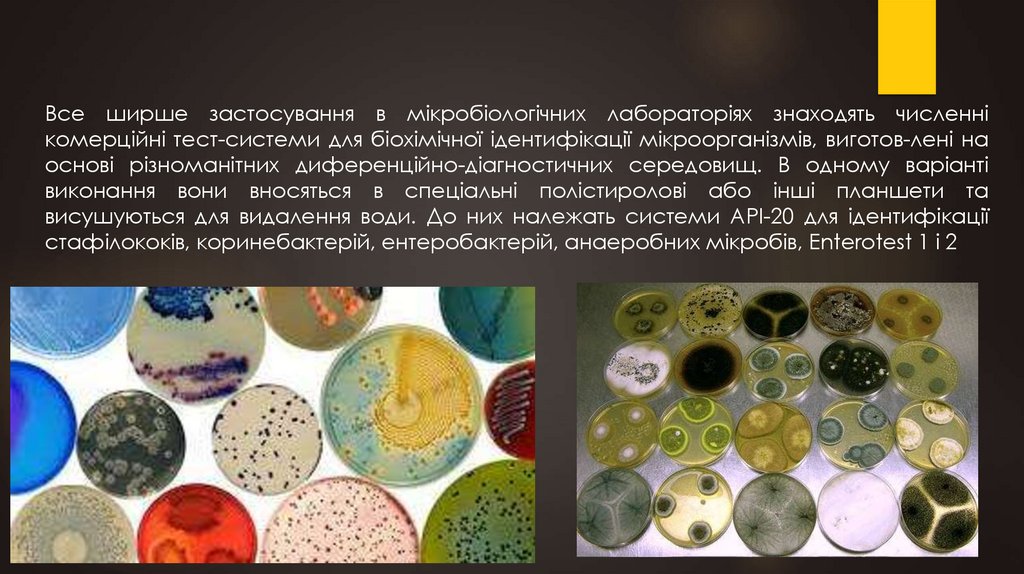

Similar presentations:
Культивування бактерій
1.
КУЛЬТИВУВАННЯ БАКТЕРІЙКАФЕДРА ІНФЕКЦІЙНИХ ХВОРОБ ТА
КЛІНІЧНОЇ ІМУНОЛОГІЇ
К.Б.Н., ДОЦЕНТ МАЛАНЧУК СВІТЛАНА
ПРАКТИЧНЕ ЗАНЯТТЯ № 4
2.
Відношення бактерій до факторів зовнішньогосередовища
Низька (психрофіли)
Температура
10-45оС (мезофили)
Висока (термофіли)
Чинники зовнішнього
середовища
Низька (ацидофіли)
Кислотність
Висока
(алкалофілиа)
Осмолярність
Висока (осмофіли,
галофіли)
3.
Відношення бактерій до кисню4.
Поживні середовища для культивуваннябактерій. Консистенція
За
консистенцією
Рідкі
Без агару
(бульйоны)
Напіврідкі
0,3-0,7% агару
Щільні
1,5-3,0% агару
(агари)
5.
Поживні середовища для культивування бактерій.Компоненти
Вода
Органічні
речовини
Мінеральні
речовини
Чинники
або
інгібітори
росту
6.
Основним регулятором надходження речовин до бактеріальної клітини єцитоплазматична мембрана. Існує чотири основні механізми надходження речовин:
– пасивна дифузія – за градієнтом концентрації, що не має субстратної
специфічності;
– полегшена дифузія – за градієнтом концентрацій, субстратспецифічна,
здійснюється за участі спеціалізованих білків переносників пермеаз, що розміщені в
мембрані;
– активний транспорт – проти градієнта концентрації, субстратспецифічний
(спеціальні білки в комплексі з пермеазами), енерговитратний (за рахунок АТФ),
речовини надходять до клітини в хімічно незміненому вигляді;
– транслокація (перенос груп) – проти градієнта концентрацій, за допомогою
фосфотрансферазної системи, енерговитратна, речовини (переважно цукри)
надходять у клітину у фосфорильованому вигляді.
7.
Поживні середовища для культивування бактерій.Прості середовища
Пептона вода
0,5-1% пептона
Мясопептоний бульйон
0,5-1% экстракта яловичини + 0,5-1% пептона
Бульйон Хоттингера
Розведення перевару Хоттінгера (бульйон з
панкреатином або тканинами підшлункової
залози)
М'ясопептоний агар
Прості рідкі середовища + 1,5-3% агару
Поживиний желатин
Булйьон + 10-15% желатина
8.
Поживні середовища для культивуваннябактерій. Прості середовища
Основні – культивація більшості патогенних
бактерій
Спеціальні – для окремих груп бактерій
Елективні – для одного виду/роду
мікробів
Середовища збагачення – для
накопичення окремих видів бактерій
Диференціально-діагностичні – вивчення
властивостей та ідентифікація бактерій
Мікро-тест системи – комерційні середовища
для експрес-діагностики
9.
Залежно від потреб бактеріологів живильні середовища поділяються на п’ять основнихгруп.
Перша група – універсальні (прості) середовища. До них належать м’ясо-пептонний
бульйон (МПБ) та м’ясо-пептонний агар (МПА). За своїм складом, наявністю живильних
речовин вони придатні для культивування багатьох видів бактерій.
Друга група – спеціальні середовища. Вони використовуються в тих випадках, коли
мікроорганізми не ростуть на простих. До них належить кров’яний, сироватковий
агари, сироватковий бульйон, асцитичний бульйон, асцит-агар та інші.
Третя група – елективні середовища, на яких мікроорганізми певного виду ростуть
швидше, більш інтенсивно, опереджають у своєму розвитку інші види бактерій.
Наприклад, 1 % лужна пептонна вода є елективним середовищем для холерних
вібріонів, середовища Ру та Леффлера – для збудників дифтерії.
Четверта група селективні середовища, які завдяки додаванню певних компонентів
(жовч, фарби, антибіотики та ін.) здатні пригнічувати розвиток одних видів
мікроорганізмів, але не впливають на інші види. Так, середовище Мюллера є
селективним для тифо-паратифозних бактерій, фуразолідоно-твіновий агар – для
коринебактерій і мікрококів. Додавання антибіотиків до складу середовищ робить їх
селективними для грибів (напр. середовище Сабуро та ін.).
П’ята група – диференціально–діагностичні середовища. Це велика група середовищ,
які дозволяють визначити певні біохімічні властивості мікроорганізмів і проводити їх
диференціацію. Вони поділяються на середовища для визначення протеолітичних,
пептолітичних, цукролітичних, гемолітичних, ліполітичних, редукуючих властивостей
(середовища Ендо, Левіна, Плоскірєва, Гісса).
10.
Все ширше застосування в мікробіологічних лабораторіях знаходять численнікомерційні тест-системи для біохімічної ідентифікації мікроорганізмів, виготов-лені на
основі різноманітних диференційно-діагностичних середовищ. В одному варіанті
виконання вони вносяться в спеціальні полістиролові або інші планшети та
висушуються для видалення води. До них належать системи АРІ-20 для ідентифікації
стафілококів, коринебактерій, ентеробактерій, анаеробних мікробів, Enterotest 1 і 2
11.
12.
У мікробіологічній практиці широко використовуються диференційно-діагностичнісередовища Ендо, Левіна, Плоскирєва, які дозволяють виявити розкладання лактози
бактеріями. Вони дозволяють проводити первинну диференціацію бактерій
кишкового тракту, що надзвичайно важливо для швидкого виділення чистих культур
з їх наступною ідентифікацією. Ці середовища є елективними для багатьох
представників родини кишкових бактерій. Випускаються вони у сухому вигляді,
тому їх приготування в лабораторіях не потребує багато часу.
13.
Середовище Ендо складається з сухогоживильного агару, 1 % лактози та індикатора
фуксину, знебарвленого розчином сульфіту
натрію.
Свіже середовище
забарвлення.
має
слабке
рожеве
При рості лактозопозитивних мікроорганізмів,
тих, що розщеплюють лактозу (E. coli), їх колонії
забарвлюються у темно-червоний колір з
металевим блиском.
Колонії
лактозонегативних
мікробів
(сальмонели, шигели) на цьому середовищі
безбарвні.
14.
До складу середовища Левіна також входитьМПА, лактоза, однозаміщений фосфат калію,
індикатори метиленовий синій, еозин.
Нативне середовище має фіолетовий колір.
Колонії лактозопозитивних бактерій мають
темно-синє забарвлення, а лактозонегативні –
рожевий відтінок.
Сухий бактоагар Плоскирєва (Бактоагар Ж)
містить у складі агар із солями жовчних кислот
лактозу, цитрат натрію, гіпосульфіт, фосфат
натрію,
брильянтовий
зелений,
соду
кальциновану, йод і нейтральний червоний.
Мікроорганізми, що розщеплюють лактозу,
утворюють колонії рожевого кольору, а ті, що її
не ферментують – безбарвні.
15.
Біохімічні властивості бактерійВони досить різноманітні. Найчастіше
досліджують
цукролітичні,
протеолітичні, пептолітичні, гемолітичні
властивості,
утворення
ферментів
декарбоксилаз, оксидази, каталази,
плазмокоагулази,
ДНК-ази,
фібринолізину, перетворення нітратів у
нітрити тощо. Для цього існують
спеціальні живильні середовища, які
засівають
мікроорганізмами
(строкатий ряд Гісса, МПБ, згорнута
сироватка, молоко та ін.). Визначення
виду збудника за його біохімічними
властивостями називається біохімічною
ідентифікацією
16.
Гемолітична активність мікроорганізмів є однією з найсуттєвіших ознак їхвірулентності, тому її визначення стало рутинною процедурою будь-якої
спеціалізованої лабораторії. З цією метою використовують кров’яний МПА.
Його готують з розтопленого та охолодженого до 45-50 °С живильного агару, до
якого додають 5-10 % дефібринованої або свіжої крові тварини (барана або
кролика). Агар з кров’ю ретельно перемішують, не допускаючи утворення піни, і
розливають у чашки Петрі.
Якщо бактерії продукують гемолізини, навколо колоній або штрихів посіву
утворюються зони просвітління на матовому червоному фоні.
За кольором гемолізу
гемолізинів (α, β, γ тощо).
(безбарвний,
зеленкуватий)
можна
визначити
тип

biology
biology








